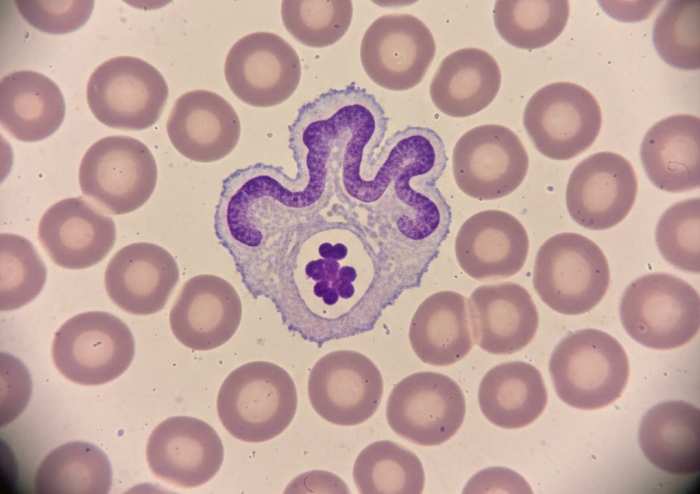
Anaplasma and Lyme Co‑infection Failure

If you have any questions or would like to share something, feel free to join our Facebook group
Tick‑borne infections are no longer single‑pathogen events. Modern epidemiology shows that a single Ixodes tick can transmit a complex microbial consortium, yet clinical practice still treats Lyme disease as an isolated entity. This disconnect has profound consequences. Anaplasma phagocytophilum, an obligate intracellular pathogen that disables neutrophils and suppresses antibody formation, creates the perfect immunological shield for Borrelia burgdorferi. The result is a diagnostic blind spot in which Lyme tests fail, symptoms progress, and patients are left without answers. Understanding this synergy is essential for accurate diagnosis, effective treatment, and prevention of long‑term disability.
How Anaplasma Immunosuppression Drives Lyme Test Failure
Anaplasma phagocytophilum, an obligate intracellular pathogen targeting neutrophilic granulocytes, functions as a silent saboteur within the immunological landscape of tick-borne disease. By hijacking neutrophils, the organism establishes a systemic immunological blind spot in which the host's primary innate defense is not merely evaded but actively repurposed. Within these cells, A. phagocytophilum inhibits the NADPH oxidase dependent respiratory burst, disrupts phagosome-lysosome fusion, and delays programmed cell death, thereby converting short-lived effector cells into transient but highly effective sanctuaries for microbial persistence. In the context of co-infection with Borrelia burgdorferi, this neutrophil-centered immune subversion acquires profound clinical significance. The interaction is not simply additive. Rather, it is synergistic, with Anaplasma mediated immunomodulation dismantling the first line of defense that would otherwise constrain early Borrelia proliferation and dissemination.
This synergy has direct implications for both pathogenesis and diagnostics. By attenuating pro-inflammatory signaling and contributing to a neutropenic environment and broader humoral immune suppression, A. phagocytophilum impairs the development of a robust and timely antibody response to B. burgdorferi. The result is a state in which standard Lyme serology, predicated on adequate IgM and IgG seroconversion, becomes intrinsically unreliable. Diagnostic sensitivity is compromised not because Borrelia is absent, but because the immune system is too functionally paralyzed to generate the serological signatures upon which current testing algorithms depend. Patients may therefore present with clinically compatible, even advanced, Lyme disease while repeatedly testing negative by ELISA and Western blot, particularly in early and subacute phases.
This article advances the thesis that failure to recognize and treat the immunosuppressive shield provided by A. phagocytophilum in co-infected individuals constitutes a critical blind spot in contemporary tick-borne disease management. By focusing narrowly on Lyme disease as a monoinfection, clinicians risk underestimating the capacity of Anaplasma to facilitate Borrelia persistence, promote tissue invasion, and undermine diagnostic accuracy. A reframing of both clinical suspicion and diagnostic strategy is urgently required, in which co-infection is assumed rather than dismissed, and in which the immunological sabotage of neutrophils is recognized as a central determinant of outcome.
Introduction: Beyond monotherapy and mono-diagnosis
The epidemiology of tick-borne disease has evolved substantially over the past several decades, yet clinical paradigms have not kept pace with this transformation. Increasingly, a single tick bite represents not the transmission of a solitary pathogen, but the inoculation of a polymicrobial consortium that may include Borrelia burgdorferi, Anaplasma phagocytophilum, Babesia species, Bartonella species, and a range of emerging agents. This ecological reality is driven by complex interactions among reservoir hosts, vector populations, land use patterns, and climate dynamics, all of which favor the expansion of Ixodes ticks and the microbial communities they carry. In this setting, the traditional conceptualization of Lyme disease as an isolated infection is no longer tenable. Instead, co-infection must be regarded as a common, clinically relevant scenario with distinct implications for pathophysiology, diagnostics, and treatment.
Despite this shift, a persistent Lyme centric bias dominates both clinical practice and public health messaging. The diagnostic and therapeutic focus remains overwhelmingly on B. burgdorferi, with other tick-borne pathogens relegated to secondary consideration, if they are considered at all. This mono-diagnostic mindset is reinforced by guideline structures, reimbursement frameworks, and laboratory algorithms that prioritize Lyme serology as the primary, and often sole, investigative tool in patients with suspected tick-borne illness. The consequence is a systematic under recognition of co-pathogens such as A. phagocytophilum, whose clinical manifestations may be nonspecific, transient, or masked by overlapping symptomatology. When Anaplasma infection is not actively sought, it is easily missed, particularly once the acute febrile phase has passed.
The clinical implications of this oversight are profound. Anaplasma phagocytophilum is not a passive bystander in co-infected hosts. As an obligate intracellular pathogen of neutrophils, it exerts a deep and multifaceted influence on host immunity. By inducing leukopenia, altering neutrophil function, and contributing to a milieu of humoral immune suppression, it can fundamentally reshape the host response to B. burgdorferi. In such a context, standard therapeutic regimens designed for isolated Lyme disease may be inadequate in both duration and scope. Monotherapy that does not explicitly account for the presence and immunological impact of Anaplasma risks leaving intact a pathogen that is actively undermining the host's capacity to clear Borrelia and to mount a detectable antibody response.
This disconnect between ecological reality and clinical practice sets the stage for chronic illness and treatment resistance. Patients with unrecognized co-infection may experience persistent or relapsing symptoms despite guideline-concordant Lyme therapy, only to be told that ongoing disease is implausible in the absence of positive serology. The possibility that diagnostic sensitivity is itself compromised by an underlying immunosuppressive process is rarely entertained. Yet this is precisely the scenario that emerges when A. phagocytophilum is allowed to operate unchecked within the neutrophil compartment. The present work argues that a failure to integrate this understanding into diagnostic and therapeutic strategies represents a critical gap in the standard of care. To move beyond monotherapy and mono-diagnosis, clinicians must adopt a framework in which co-infection is not an exotic exception but a default consideration, and in which the immunological sabotage orchestrated by Anaplasma is recognized as a central driver of both clinical course and diagnostic failure.
Pathophysiology: Hijacking the Neutrophil
The pathophysiology of Anaplasma phagocytophilum infection represents one of the most sophisticated examples of immune subversion among tick-borne pathogens. As an obligate intracellular pathogen with strict tropism for neutrophilic granulocytes, A. phagocytophilum exploits the very cells designed to serve as the host's first line of antimicrobial defense. Neutrophils are typically short-lived, highly reactive effector cells that rely on rapid phagocytosis, oxidative killing, and tightly regulated apoptosis to contain microbial threats. By infiltrating this compartment, Anaplasma gains access to a privileged immunological niche that is both mobile and central to innate immunity. The organism enters neutrophils through receptor-mediated endocytosis, subsequently residing within a membrane-bound vacuole that it modifies to prevent maturation into a bactericidal phagolysosome. This early manipulation sets the stage for a cascade of intracellular disruptions that fundamentally alter neutrophil function.
One of the most critical mechanisms of immune sabotage is the inhibition of the NADPH oxidase complex, which is responsible for generating the respiratory burst. This oxidative burst is essential for the rapid killing of engulfed pathogens. A. phagocytophilum interferes with the assembly and activation of this enzyme system, effectively neutralizing the neutrophil's primary antimicrobial weapon. Without the ability to generate reactive oxygen species, the neutrophil becomes a permissive environment rather than a hostile one. In parallel, the pathogen blocks phagosome-lysosome fusion, preventing exposure to degradative enzymes and acidic conditions. This dual blockade ensures that the intracellular vacuole remains a safe, non-lethal compartment in which the bacterium can replicate.
The pathogen's manipulation extends beyond simple evasion of killing mechanisms. A. phagocytophilum actively delays neutrophil apoptosis, prolonging the lifespan of a cell type that is normally programmed for rapid turnover. This delay is not merely a passive consequence of infection but a deliberate strategy that allows the bacterium to maintain a stable intracellular habitat. By extending neutrophil survival, Anaplasma ensures continued dissemination throughout the bloodstream and peripheral tissues. These altered neutrophils circulate widely, carrying the pathogen to new sites and facilitating systemic infection.
The consequences of this neutrophil hijacking extend far beyond the intracellular environment. Infected neutrophils exhibit impaired chemotaxis, reduced adhesion, and diminished capacity to coordinate inflammatory responses. They fail to respond appropriately to microbial signals and are unable to recruit additional immune cells to sites of infection. This creates a functional immunological blind spot in which early microbial proliferation can proceed unchecked. In the context of co-infection with Borrelia burgdorferi, this disruption becomes particularly consequential. Neutrophils are among the first responders to Borrelia invasion, and their rapid mobilization is essential for containing early spirochetal dissemination. When these cells are incapacitated or repurposed by Anaplasma, Borrelia encounters a weakened defensive landscape that allows it to migrate more freely through connective tissue, evade early clearance, and establish persistent infection.
The neutropenic environment that often accompanies Anaplasma infection further compounds this vulnerability. As circulating neutrophil counts decline, the host's capacity to mount an effective innate response diminishes. This reduction in cellular defenses is accompanied by broader humoral immune suppression, as cytokine signaling becomes dysregulated and antigen presentation is impaired. The result is a systemic weakening of immune surveillance that benefits not only Anaplasma but also any co-infecting pathogen. In this sense, A. phagocytophilum functions as a force multiplier, dismantling the host's primary defense architecture and creating conditions that favor the persistence and dissemination of Borrelia.
The pathophysiological interplay between these organisms underscores the importance of recognizing Anaplasma not as a secondary or incidental pathogen but as a central driver of immune dysfunction in co-infected patients. Its ability to hijack neutrophils, suppress innate immunity, and create a permissive environment for Borrelia represents a critical mechanism through which diagnostic and therapeutic failures arise. Understanding this process is essential for developing more effective clinical strategies that address the full complexity of tick-borne co-infections.
Synergistic Immunomodulation: Clearing the Path for Borrelia
The immunological consequences of Anaplasma phagocytophilum infection extend far beyond the intracellular sabotage of neutrophils. Once the pathogen has established itself within the granulocyte compartment, its influence radiates outward into the broader immune network, reshaping host defenses in ways that profoundly benefit Borrelia burgdorferi. This interaction is not a simple coexistence of two pathogens within the same host. It is a coordinated disruption in which Anaplasma actively dismantles the immunological architecture that would otherwise constrain Borrelia during the earliest and most critical phases of infection. The resulting synergy creates a permissive environment in which B. burgdorferi can disseminate more rapidly, evade immune detection, and establish persistent infection in tissues that are normally well protected.
A central feature of this systemic immunomodulation is the development of leukopenia and thrombocytopenia, both of which are hallmarks of acute Anaplasma infection. The reduction in circulating leukocytes, particularly neutrophils and lymphocytes, weakens the host's capacity for immune surveillance. With fewer effector cells available to patrol peripheral tissues, the early containment of Borrelia becomes significantly impaired. This is especially consequential during the initial days following a tick bite, when the innate immune response plays a decisive role in limiting spirochetal spread. In a neutropenic environment, Borrelia encounters minimal resistance as it migrates through the extracellular matrix, enters the bloodstream, and seeds distant sites such as synovial tissue, cardiac structures, and the central nervous system.
The immunosuppressive effects of Anaplasma are not limited to cell counts. The pathogen exerts a profound influence on cytokine signaling, skewing the host response away from the pro-inflammatory pathways required for effective Borrelia clearance. Infected neutrophils exhibit reduced production of key cytokines such as IL-1beta, IL-6, and TNF-alpha, all of which are essential for orchestrating the early inflammatory response. This suppression blunts the activation of macrophages, dendritic cells, and natural killer cells, creating a cascade of downstream effects that culminate in broad humoral immune suppression. Antigen presentation becomes inefficient, T cell activation is delayed, and B cell maturation is impaired. In this altered immunological landscape, Borrelia is able to replicate and disseminate with far greater efficiency than in a host with intact innate and adaptive responses.
The suppression of pro-inflammatory signaling also alters the kinetics of Borrelia dissemination. Under normal circumstances, the early inflammatory response generates a localized containment zone that restricts spirochetal movement. When this response is muted, Borrelia can penetrate deeper into tissues and establish early reservoirs that are difficult to eradicate. This is particularly evident in the joints, where the absence of robust neutrophil recruitment allows Borrelia to colonize synovial tissue and initiate the inflammatory cascades that later manifest as Lyme arthritis. Similarly, reduced cytokine signaling facilitates early neuroinvasion, allowing the pathogen to cross the blood-brain barrier and establish infection within the central nervous system before the host mounts an adequate defense.
The synergy between Anaplasma and Borrelia is further amplified by the disruption of platelet function. Thrombocytopenia impairs vascular integrity and alters endothelial signaling, creating microenvironments that favor Borrelia adhesion and transmigration. Platelets also play a role in innate immunity through the release of antimicrobial peptides and the modulation of leukocyte recruitment. Their depletion removes yet another layer of defense, compounding the vulnerabilities created by neutrophil dysfunction and cytokine suppression.
Taken together, these systemic effects illustrate that Anaplasma phagocytophilum does not merely coexist with Borrelia burgdorferi. It actively facilitates Borrelia's success by dismantling the host's defensive infrastructure at multiple levels. The resulting immunological void allows Borrelia to behave more aggressively, disseminate more rapidly, and evade detection more effectively than it could in isolation. This synergy underscores the clinical danger of treating Lyme disease without recognizing the immunosuppressive shield provided by Anaplasma. Failure to address this interaction leads not only to diagnostic blind spots but also to therapeutic failures, as standard Lyme-directed regimens may be insufficient in a host whose immune system has been strategically disarmed.
The Diagnostic Paradox: Why Borrelia Tests May Fail
The diagnostic challenges that arise in the setting of Borrelia burgdorferi and Anaplasma phagocytophilum co-infection are not incidental laboratory artifacts. They are the predictable consequence of a profoundly altered immunological landscape in which the host is unable to mount the very responses that standard Lyme diagnostics are designed to detect. The paradox is striking. Clinicians rely heavily on serological assays to confirm Lyme disease, yet the presence of Anaplasma creates a physiological state in which seroconversion is delayed, blunted, or entirely absent. This disconnect between biological reality and diagnostic expectation leads to a cycle of false reassurance, missed treatment opportunities, and prolonged morbidity.
At the core of this paradox is the suppression of humoral immunity that accompanies Anaplasma infection. The pathogen’s manipulation of neutrophils and its systemic immunomodulatory effects extend into the adaptive immune compartment, where B cell activation and antibody production are critically dependent on intact cytokine signaling and antigen presentation. When neutrophils fail to generate appropriate inflammatory cues, dendritic cells receive insufficient stimulation to mature and migrate to lymphoid tissues. T cell priming becomes inefficient, and the downstream activation of B cells is delayed. In this environment, the production of Borrelia-specific IgM and IgG antibodies is markedly impaired. Serological assays such as ELISA and Western blot, which depend on the detection of these antibodies, therefore exhibit reduced diagnostic sensitivity. A negative test in this context does not reflect the absence of Borrelia. It reflects the inability of the immune system to produce measurable antibodies due to the immunosuppressive influence of Anaplasma.
This suppressed seroconversion creates what can be described as a false negative loop. Patients present with symptoms consistent with early or disseminated Lyme disease, yet their laboratory results fail to meet the serological criteria required for diagnosis. Clinicians, guided by rigid testing algorithms, may dismiss the possibility of Lyme disease despite compelling clinical evidence. The patient is told that the negative test is definitive, even though the underlying immunological dysfunction makes such an interpretation scientifically unsound. As symptoms progress, repeat testing may remain negative, reinforcing the erroneous conclusion that Lyme disease is not present. This loop can persist for months, during which Borrelia continues to disseminate and establish persistent infection in tissues that are increasingly difficult to treat.
The diagnostic challenges extend beyond serology. Polymerase chain reaction assays, which detect microbial DNA directly, are often assumed to bypass the limitations of antibody-based testing. However, intracellular pathogens such as Anaplasma complicate PCR sensitivity in peripheral blood. The sequestration of infected neutrophils, the transient nature of bacteremia, and the rapid migration of Borrelia into tissues all reduce the likelihood of detecting spirochetal DNA in blood samples. Furthermore, the neutropenic environment induced by Anaplasma reduces the overall cellular material available for analysis, diminishing the probability that Borrelia DNA will be captured in the sample. Even when PCR is performed on synovial fluid or cerebrospinal fluid, the patchy distribution of Borrelia and the timing of sample collection can lead to false negatives.
The reliance on serology as the primary diagnostic tool for Lyme disease becomes particularly problematic in this context. The two-tier testing algorithm, which requires a positive ELISA followed by confirmatory Western blot, was designed for immunocompetent hosts with predictable antibody kinetics. It was not designed for patients experiencing humoral immune suppression due to an active intracellular infection. Yet clinical guidelines rarely acknowledge this limitation. As a result, patients with co-infection are systematically disadvantaged by a diagnostic framework that fails to account for the immunological sabotage orchestrated by Anaplasma.
The diagnostic paradox is therefore not a theoretical concern. It is a real and consequential barrier to timely treatment. By suppressing seroconversion, altering cytokine signaling, and reducing the sensitivity of both serological and molecular assays, Anaplasma creates a diagnostic blind spot in which Borrelia can thrive undetected. Recognizing this paradox is essential for improving clinical outcomes. Without an understanding of how co-infection undermines diagnostic accuracy, clinicians will continue to rely on tests that are fundamentally unsuited to the immunological conditions present in these patients.
Clinical Oversights and Social Implications
The clinical landscape surrounding tick-borne disease remains constrained by a narrow diagnostic and therapeutic framework that fails to account for the complexity of polymicrobial infections. This limitation is particularly evident in the persistent under recognition of Anaplasma phagocytophilum as a co-pathogen capable of reshaping the entire immunological context in which Borrelia burgdorferi infection unfolds. Despite decades of evidence demonstrating that Ixodes ticks frequently harbor multiple pathogens simultaneously, the prevailing standard of care continues to prioritize Lyme disease testing while relegating co-infections to an afterthought. This oversight is not merely a matter of incomplete laboratory work. It is a systemic failure that reverberates through clinical decision making, insurance structures, and patient experiences, ultimately contributing to prolonged illness and preventable disability.
One of the most striking gaps lies in the limited use of comprehensive co-infection panels. Clinicians often rely exclusively on Lyme serology, even when patients present with symptoms that are atypical for isolated Borrelia infection or that align more closely with Anaplasma, Babesia, or Bartonella. The reluctance to order broader testing stems from multiple factors. Some physicians assume that co-infections are rare, despite epidemiological data showing that co-transmission is common in endemic regions. Others are constrained by guidelines that emphasize Lyme testing while offering minimal direction on when to evaluate for additional pathogens. Insurance protocols further reinforce this narrow approach by covering only the most basic assays and denying reimbursement for more advanced or specialized diagnostics. As a result, many patients undergo incomplete evaluations that fail to identify the immunosuppressive processes driving their clinical deterioration.
Economic barriers compound this problem. The most sensitive and informative tests for tick-borne co-infections, such as T cell-based Elispot assays, expanded cytokine panels, and immune profiling tools like CD57 quantification, are often available only through private laboratories. These tests can be prohibitively expensive, placing them out of reach for many patients. Insurance companies frequently classify them as experimental or unnecessary, despite their utility in detecting infections that evade standard serology. This creates a two-tiered diagnostic system in which only those with financial means can access the testing required to uncover the full spectrum of their illness. Patients without such resources are left with incomplete data, inconclusive results, and a clinical narrative that fails to capture the true complexity of their condition.
The social and psychological consequences of these diagnostic limitations are profound. Patients who remain symptomatic despite negative Lyme serology often encounter skepticism from clinicians who interpret these results as definitive proof that infection is absent. This dynamic can lead to a form of medical gaslighting in which patients are told that their symptoms are psychosomatic, stress-related, or indicative of unrelated chronic conditions. The possibility that an undiagnosed Anaplasma infection has suppressed seroconversion is rarely considered, even though this mechanism is well documented in the scientific literature. Over time, patients may internalize this skepticism, doubting their own experiences and delaying further care. The erosion of trust between patient and clinician becomes an additional barrier to effective treatment.
The consequences extend beyond individual encounters. When patients are repeatedly dismissed due to seronegative results, they may withdraw from the healthcare system altogether, seeking alternative or unregulated treatments. This shift can expose them to misinformation, unsafe therapies, and further delays in receiving appropriate antimicrobial care. Meanwhile, the untreated immunosuppressive effects of Anaplasma continue to facilitate Borrelia persistence, increasing the likelihood of chronic symptoms that are more difficult to reverse. The social burden of this cycle is substantial, encompassing lost productivity, long-term disability, and significant emotional distress.
The clinical oversights surrounding co-infection are therefore not isolated errors but manifestations of a broader structural problem. The healthcare system remains anchored to a Lyme-centric model that fails to account for the synergistic interactions between pathogens and the immunological sabotage orchestrated by Anaplasma. Without a shift toward comprehensive diagnostic strategies and a recognition of the immunosuppressive shield that co-infections create, patients will continue to fall through the gaps of an outdated framework. Addressing these oversights requires not only improved clinical awareness but also systemic changes in insurance coverage, diagnostic guidelines, and medical education. Only then can the full spectrum of tick-borne disease be recognized and treated with the rigor it demands.
Conclusion
The interplay between Borrelia burgdorferi and Anaplasma phagocytophilum represents one of the most clinically consequential yet persistently underestimated dynamics in contemporary infectious disease medicine. Throughout this analysis, a consistent theme emerges. Anaplasma is not a peripheral co-infection, nor a benign accompaniment to Lyme disease. It is a force multiplier that reshapes the immunological terrain in ways that directly determine the trajectory of Borrelia infection. By infiltrating neutrophils and converting them into dysfunctional, immunologically silent reservoirs, A. phagocytophilum dismantles the host’s primary defensive barrier at the precise moment when early containment of Borrelia is most critical. This sabotage extends outward into the systemic immune network, creating a neutropenic and cytokine-suppressed environment that allows Borrelia to disseminate with unusual speed and persistence.
The consequences of this synergy are profound. Diagnostic sensitivity collapses under the weight of humoral immune suppression, leaving clinicians dependent on serological tools that cannot detect what the immune system has failed to produce. Patients become trapped in a diagnostic paradox in which the absence of antibodies is misinterpreted as the absence of infection, even as Borrelia continues to invade joints, cardiac tissue, and the nervous system. The resulting false negative loop is not a rare anomaly but an expected outcome when Anaplasma is allowed to operate unchecked. This reality exposes a critical flaw in the current standard of care, which remains anchored to a Lyme-centric model that does not account for the immunological sabotage orchestrated by co-infection.
The clinical and social implications of this oversight are far-reaching. Patients are frequently denied appropriate treatment, dismissed due to seronegative results, or forced to navigate a fragmented healthcare system that does not recognize the complexity of their illness. Economic barriers further restrict access to advanced diagnostics that could reveal the underlying immunosuppressive processes at work. The cumulative effect is a pattern of prolonged morbidity, preventable disability, and profound psychological distress. These outcomes are not the result of microbial inevitability but of systemic failure to adapt diagnostic and therapeutic strategies to the biological realities of co-infection.
The path forward requires a fundamental shift in clinical practice. Any patient presenting with symptoms consistent with Lyme disease must be evaluated with the assumption that co-infection is possible, if not probable. Comprehensive tick-borne panels should be standard rather than exceptional, and clinicians must recognize that negative Lyme serology cannot be considered definitive in the presence of immunosuppressive pathogens such as Anaplasma. Treatment strategies must be tailored to the altered immune landscape of co-infected patients, with longer antimicrobial courses and immune monitoring integrated into routine care. This approach is not an expansion of care but a correction of longstanding diagnostic blind spots.
In summary, Anaplasma phagocytophilum is a silent saboteur whose influence extends far beyond its own intracellular niche. By undermining innate and humoral immunity, it creates the conditions in which Borrelia burgdorferi can persist, disseminate, and evade detection. Recognizing this synergy is essential for preventing the diagnostic failures and therapeutic shortcomings that have plagued Lyme disease management for decades. A comprehensive, co-infection-centered approach is not merely advisable. It is indispensable for safeguarding patients from the long-term consequences of untreated or inadequately treated tick-borne disease.